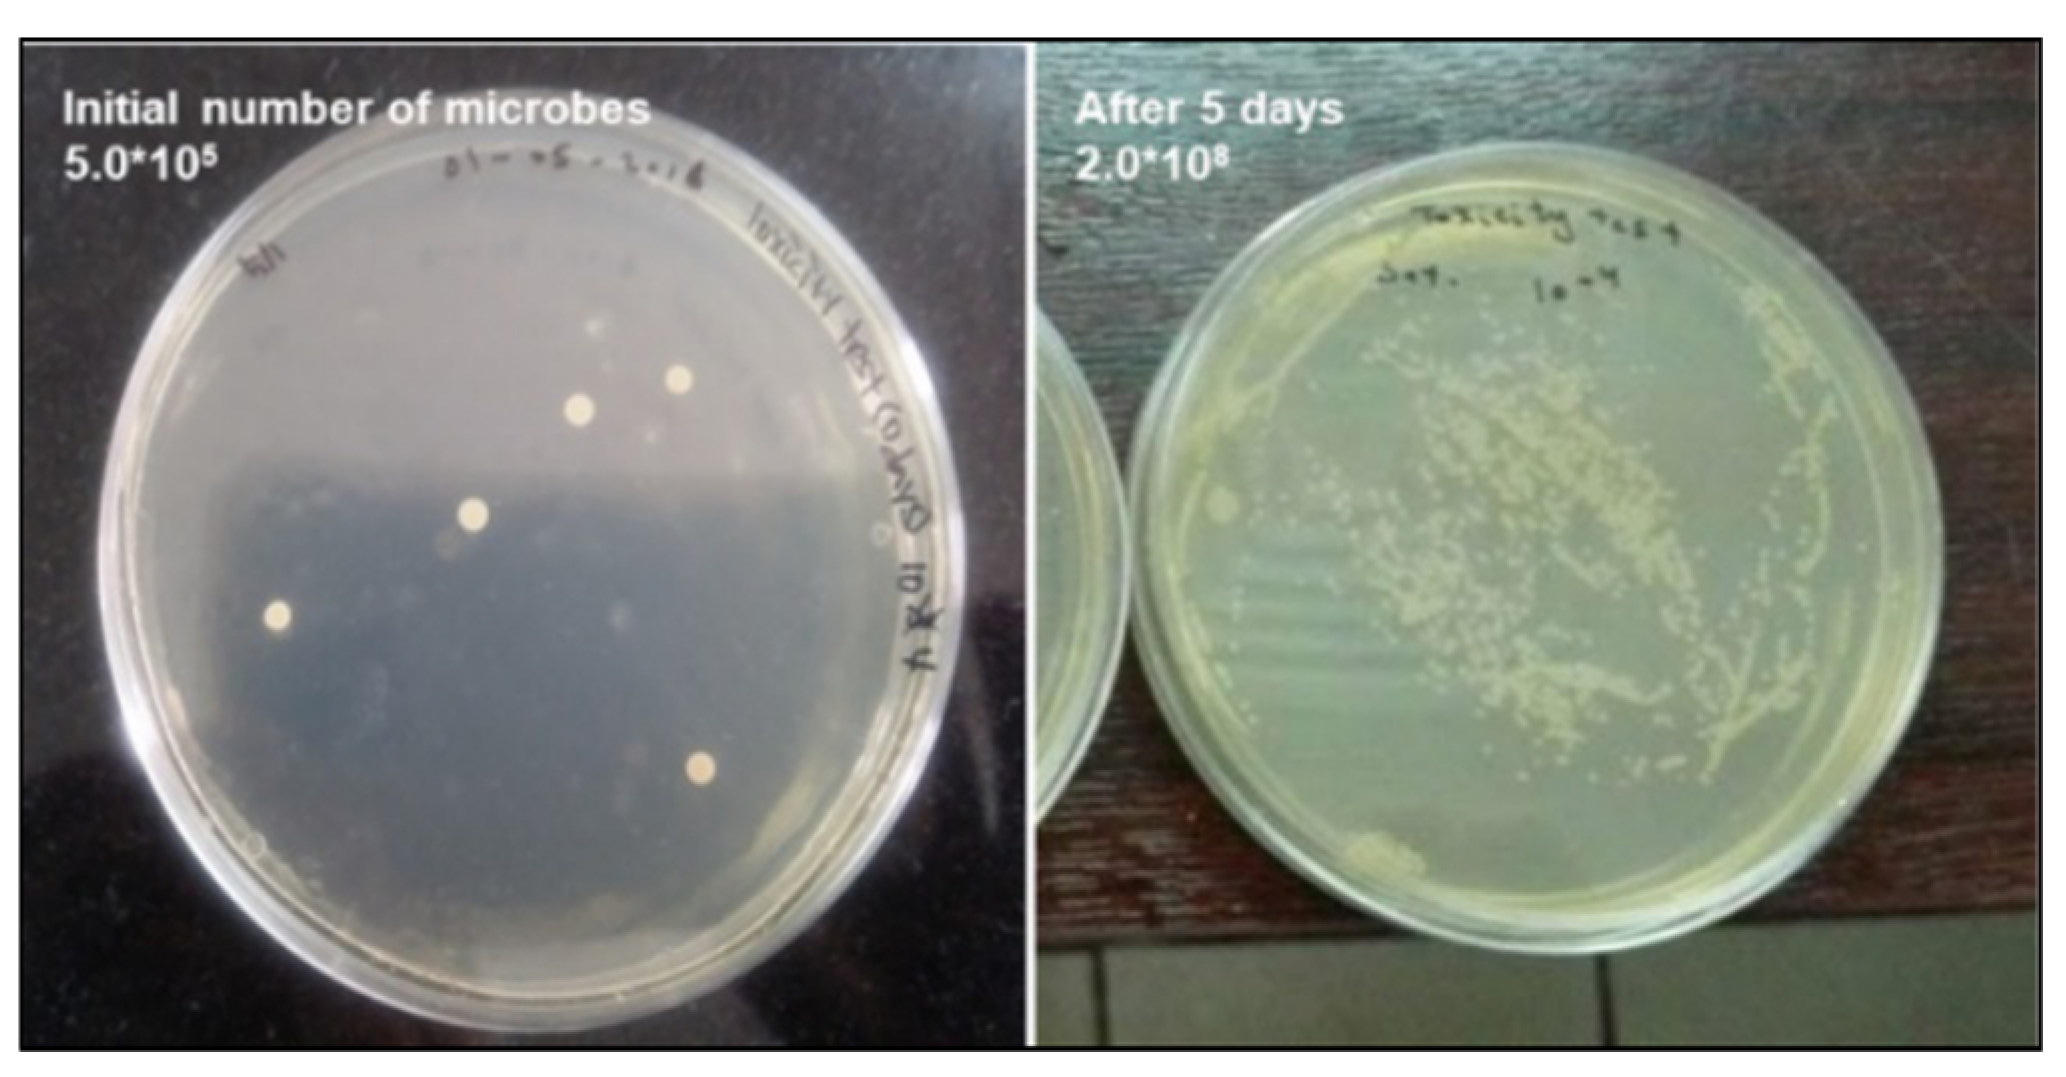
Preprints 117874 g008

1. Introduction
Crude oil spill contamination has become a significant cause of environmental degradation worldwide. In particular, approximately 0.08%-0.4% of crude oil spills into the sea during extraction from offshore operations. In addition to contamination from oil spills at onshore production facilities, oil spills have serious impacts on soil and groundwater environments, air quality, and ecosystems [
1].
The largest oil spill in human history occurred during the Second Gulf War, when Iraq invaded Kuwait in 1990–1991. This resulted in the destruction of >700 oil wells and spillage of large quantities of crude oil [
2].
Oil sludge is also generated during the transportation and storage of crude oil and the downstream refining process, which has a detrimental impact on the surrounding environment and ecosystem [
3].
Crude oil and sludge generated during storage and refining contain a wide range of volatile and non-volatile substances, the majority of which are highly volatile [
4]. Volatilization of these substances contributes significantly to soil pollution. Furthermore, if these substances are spilled into the soil or groundwater, they block pores in the soil and reduce soil permeability, which in turn degrades the ecological environment [
5].
They also contain toxic substances such as polycyclic aromatic hydrocarbons (PAHs), which have significant adverse effects on the surrounding environment and ecological systems [
6]. PAHs immobilized in the soil from spilled crude oil or oil sludge are highly recalcitrant and likely to be persistent organic pollutants that cannot be degraded by indigenous microorganisms [
7].
Therefore, the remediation of crude oil-contaminated soils presents a technical challenge. Bioremediation and physicochemical remediation have been applied to soils contaminated with low concentrations of crude oil; however, the efficacy of these approaches is highly influenced by the composition of the spilled crude oil [
8].
Soil contamination resulting from the spillage of heavy crude oils and other similar substances persists longer period of time than that caused by light crude oils [
9]. Furthermore, the spread of contamination is relatively limited because of the low fluidity of contaminants. Consequently, the area surrounding the source of contamination was characterized by a high concentration of petroleum. Consequently, in comparison to contamination by relatively low-density hydrocarbon oils, such as light crude oil, it is not straightforward to reduce contamination through typical soil remediation or restoration treatments. Indeed, some experts have suggested that there are no alternative treatment methods except for incineration and landfill waste.
Thermal desorption technology applies heat to the targeted contaminated soil to improve its viscosity and facilitate the desorption of crude oil from soil particles [
10]. In certain instances, thermal desorption may also induce a combustion reaction, resulting in the release of desorbed crude oil into the atmosphere.
However, the economic viability of thermal desorption technology is limited by the requirement of a significant input of energy to raise the temperature to a high level for direct or indirect thermal desorption, as well as the emission of a considerable quantity of greenhouse gases (GHGs), including CO
2 during thermal desorption and post-combustion processes [
11].
The pyrolytic remediation of crude oil-contaminated soil has a similar effect [
12]. Pyrolytic thermal treatment should be conducted via thermal conduction with limited energy efficiency. To build a large-scale commercial pyrolytic treatment facility, the capital expenditure (CAPEX) must be high. In contrast, low-temperature thermal desorption (LTTD) is conducted using thermal radiation via a direct-fired system; therefore, large-scale operation with high throughput and low operational expenditure (OPEX) can be achieved.
In this study, high-temperature thermal desorption (HTTD) and LTTD processes with limited oxygen were compared for the remediation efficiency of high-concentration crude oil-contaminated soil [
13].
The resulting environmental performance was evaluated. Furthermore, the treated soil obtained through the LTTD process possessed properties similar to those of biochar. This study was conducted to assess its suitability as a soil amendment.
2. Materials and Methods
2.1. Basic Characterization of High-Concentration Crude Oil-Contaminated Soil
Crude oil spilled during drilling has been left for decades in a desert climate and has been mixed with soil, showing semi-solid physical properties. To analyze the contamination concentration, the concentration of total petroleum hydrocarbons (TPH) in the crude oil-contaminated soil was measured and analyzed using gas chromatography (GC) while measuring TPH using the gravimetric method EPA 9071B method in
Figure 1.
The Soxhlet extraction method was employed using n-hexane as the solvent, and TPH were analyzed at an average of 9–11% (90,000 mg/kg). The TPH content of the same soil sample measured using GC/flame ionization detection (FID) was approximately 35,000 mg/kg-soil.
The GC/FID measures the carbon in crude oil in the range of C10–C40, whereas the n-hexane extraction method (EPA 9071B) measures the weight extracted from the entire crude oil. Consequently, TPH results differed. The GC/FID TPH value was approximately 31% of the HEM TPH value. This result confirms that the heavy fraction of crude oil is high, unlike diesel and gasoline.
The Saturated, Aromatic, Resin, and Asphaltene (SARA) analyses demonstrated that the resin and asphaltene components collectively constituted approximately 50% of the total crude oil components [
2]. Asphaltene is the most polar and large molecular weight polymer in crude oil and tends to persist as a residue, such as coke, throughout the refining process. The resin component is analogous to the asphaltene component; however, it has a smaller molecular weight, is soluble in n-heptane, and is insoluble in propane.
2.2. Thermal Decomposition Characteristics of Contaminants
The TPH analysis of the crude oil contaminant revealed the presence of a considerable quantity of the heavy fraction in
Figure 2. In contrast, SARA analysis indicated that approximately 80% of the crude oil pollutants comprised of resin and asphaltene.
Thermal Gravimetric Analysis (TGA) and Differential Scanning Calorimeter (DSC) analysis were performed from 25℃ to 800℃ at a ramp rate of 10℃/min. The TGA/DSC test was conducted under aerobic and anaerobic conditions. And the actual conditions of direct fired thermal desorption are expected to be between them. From TGA/DSC results, mass loss happened in the range of 250–500℃.
The GC/FID measures the carbon in crude oil in the range of C10–C40, whereas the n-hexane extraction method (EPA 9071B) measures the weight extracted from the entire crude oil. Consequently, TPH results differed. The GC/FID TPH value was approximately 31% of the HEM TPH value. This result confirms that the heavy fraction of crude oil is high, unlike diesel and gasoline.
The Saturated, Aromatic, Resin, and Asphaltene (SARA) analyses demonstrated that the resin and asphaltene components collectively constituted approximately 50% of the total crude oil components [
2]. Asphaltene is the most polar and large molecular weight polymer in crude oil and tends to persist as a residue, such as coke, throughout the refining process. The resin component is analogous to the asphaltene component; however, it has a smaller molecular weight, is soluble in n-heptane, and is insoluble in propane.
2.3. Thermal Desorption
Thermal desorption can be described as a two-step process. The kiln process involves the direct transfer of heat from the burner to the contaminant source, which vaporizes the organic contaminant and separates it from the soil. Secondary oxidation occurs in a high-temperature post-combustion chamber (PCC), where the vaporized and desorbed off-gas is completely oxidized.
The thermal desorption process comprises a grizzly, inlet hopper, inlet conveyor, rotary kiln, outlet conveyor, rotary kiln, cyclone, PCC, heat exchanger, semi-dry reactor, baghouse, and stack, which collectively facilitate the processing of the gas stream in
Figure 3. In contrast to HTTD, LTTD operates in an oxygen-limited environment by controlling an inlet air valve installed as an additional blower on the kiln body. Indirect-fired thermal desorption kilns are also applicable, although the efficiency of heat transfer tends to be lower.
2.4. Characteristics of Remediated Soil as a Function of Thermal Desorption Temperature
As shown in
Table 1, the average TPH content of the contaminated soil is 10%. The TPH content of the remediated soil was <1%, thereby satisfying the remediation standards of the country. In particular, LTTD was sufficient to meet the remediation standards [
5].
The primary distinction between HTTD and LTTD processes lies in the quantity of gas (GHG) produced by the thermal decomposition of the crude oil contaminant at kiln temperature. In LTTD, where oxygen is limited to approximately 50% of the crude oil contaminant, it is not gasified but fixed onto the soil in the form of coke of a carbonized residue. It can be assumed that this carbonization has a carbon sequestration effect.
In LTTD, it was anticipated that the hydrocarbons would react with oxygen to become partially oxidized hydrocarbons with functional groups such as ketones, carboxylic acids, and aldehydes as intermediates [
14]. Following this low-temperature oxidation reaction, the partially oxidized hydrocarbons undergo further reactions via dehydrogenation and condensation to produce carbonized residues. Therefore, the LTTD process produces low off-gas emissions. In HTTD, most hydrocarbon pollutants are directly converted into off-gases via thermal decomposition [
15].
As shown in Table S, the throughput of contaminated soil increases from 4.5 tons/h at 500℃ to 7.5 tons/h at 300℃, which was an inverse 60% increase in throughput depending on the difference in kiln temperature. Moreover, the amounts of fuel, water, and gas generated tended to decrease at low kiln temperatures.
Table 2.
Comparison of Throughput, Energy, and Water Consumption under Different Temperatures.
Table 2.
Comparison of Throughput, Energy, and Water Consumption under Different Temperatures.
| Classification |
Unit |
High Temp |
Low Temp |
| Throughput |
Mt/h |
4.5 |
7.5 |
Resident Time
Kiln Temperature
Fuel Consumption (Kiln)
Post Combustion Chamber (PCC)
Fuel Consumption (PCC)
Water Consumption
Dust Emission
Fuel Consumption per Soil Ton
Water Consumption per Soil Ton
Electricity Consumption per Soil Ton
CO2 Emission per Soil Ton
|
min
℃
L/h
℃
L/h
Mt/h
Mt/h
L/Mt-Soil
Mt-Water/Mt-Soil
kWh/Mt-Soil
Mt-CO2/Mt-Soil
|
30
500
61
850
158
4.092
0.18
48.7
0.8
48.2
0.04
|
30
300
67
850
220
3.602
0.115
38.3
0.55
28.9
0.015
|
A comparison of fuel usage per ton of contaminated soil revealed a 22% reduction in fuel consumption, from 38.3 liters per ton at low temperature to 48.7 liters per ton at high temperatures. In addition to the notable savings in water and electricity, the amount of GHG generated was also reduced by approximately 40% at low temperatures compared to that at high temperatures, assuming that only CO2 was generated by the combustion of crude oil contaminants. Hydrocarbons that were not converted into GHGs adhered to the surface of the treated soil in a biochar-like form due to carbon sequestration.
LTTD-treated soil with biochar-like coating was analyzed for pH, water-holding capacity (WHC), cation-exchange capacity (CEC), and seed germination for beneficial reuse for soil amendment.
2.5. Life Cycle Assessment(LCA)
This study employed the Life-cycle Assessment (LCA) technique for the environmental impact assessment. LCA is a technique that aggregates and evaluates the inputs, outputs, and environmental impacts of a product or service throughout its life cycle [
16]. This encompasses the acquisition, transportation, processing (manufacturing and processing), use, and disposal of the raw materials. The analysis was conducted according to the four steps prescribed by ISO 14040: objective and scope setting, inventory analysis, impact assessment, and interpretation of results. The detailed methodology for each step is as follows.
2.5.1. Goal and Scope
The objective of this study was to compare the life-cycle environmental impacts of HTTD and LTTD on the remediation of high-concentration crude oil-contaminated soil. HTTD is a process utilized for the remediation of high-concentration crude oil-contaminated soil from oilfield sites. The contaminated soil was transported to a treatment facility approximately 50 km from the oilfield site. The thermal desorption process includes hoppers, conveyors, rotary kilns, cyclones, oxidation chambers, heat exchangers, and baghouses.
The data associated with the HTTD process were obtained from the operation records for certain periods. Data from the LTTD operation were also obtained from the same direct-fired Thermal Desorption Unit (TDU) with a low-temperature controlled air inlet blower valve to maintain an oxygen-limited atmosphere inside the kiln [
17].
2.5.2. Assumptions and Limitations
The following assumptions and limitations were applied in this study:
It was not possible to match the treatment efficiency of HTTD and LTTD; therefore, the same treatment efficiency was assumed for 1% TPH in the final treated soil (
Table 1).
The impact of the installation of soil treatment facilities and TDU was excluded from the life-cycle environmental impact analysis.
All air emissions except CO2 were assumed to be CO2 because it was impossible to measure trace amounts of substances in the final emissions.
For the LCI database used to conduct the inventory analysis and impact assessment, the regional scope was set to the entire world (GLO), and for the electricity use database, Region A was set as the regional scope.
2.5.3. Life Cycle Inventory
One year of input-output data was collected from the site for each stage of the entire process, and inputs were quantified by a functional unit based on the distance traveled and time used by the equipment in the excavation, transportation, and yard stacking stages. The inputs and outputs of the processing stage were quantified as functional units based on actual measurements. For inputs and outputs other than CO
2 emissions, which was the elementary flow emitted from the processing stage, an inventory analysis was performed by connecting the LCI DB of Ecoinvent 3.9.1V [
18]. The list of inputs and outputs for each step quantified by the functional unit is shown in
Table 3.
2.5.4. Life Cycle Impact Assessment
In this study, the EF 3.1 impact assessment methodology developed by the EU JRC was applied to derive the life-cycle environmental impact of the thermal desorption process according to the process temperature. Given that most inputs in the process were derived from fossil fuels and that emissions had a significant impact on global warming, an impact assessment was conducted by focusing on the abiotic depletion potential (ADP) and global warming potential (GWP) impact categories [
19].
2.5.5. Life Cycle Analysis
The ADP (fossil fuels) and GWP impacts of the HTTD and LTTD processes were calculated, and a step-by-step contribution analysis was performed to determine the extent to which each step contributed to the impacts. Finally, we compared the environmental impacts of HTTD and LTTD by impact category to estimate the environmental impacts that could be reduced through low-temperature treatment when treating high-concentration crude oil-contaminated soil [
20].
3. Results and Discussion
3.1. Life Cycle Environmental Impact of HTTD
The results of the environmental impact analysis of HTTD by impact category and the contribution of each stage are shown in
Table 4 and
Figure 5. The total ADP environmental impact of the HTTD treatment was calculated as 1.63E-04 MJ/f.u., with the transportation stage accounting for the largest percentage of the total environmental impact at 5.69E-05 MJ/f.u., representing 34.9% of the total environmental impact. The impact of diesel use in the oxidation chamber was 5.27E-05 MJ/f.u., accounting for 32.3%, and thus constituted the second-largest contributor to the total environmental impact after transportation. In addition to transportation and oxidation chamber diesel use, electricity use (16.4%), rotary kiln diesel use (12.5%), and water use (3.1%) contributed to the environmental impact.
3.1. Life Cycle Environmental Impact of HTTD
The results of the environmental impact analysis of HTTD by impact category and the contribution of each stage are shown in
Table 4 and
Figure 5. The total ADP environmental impact of the HTTD treatment was calculated as 1.63E-04 MJ/f.u., with the transportation stage accounting for the largest percentage of the total environmental impact at 5.69E-05 MJ/f.u., representing 34.9% of the total environmental impact. The impact of diesel use in the oxidation chamber was 5.27E-05 MJ/f.u., accounting for 32.3%, and thus constituted the second-largest contributor to the total environmental impact after transportation. In addition to transportation and oxidation chamber diesel use, electricity use (16.4%), rotary kiln diesel use (12.5%), and water use (3.1%) contributed to the environmental impact.
3.2. Life Cycle Environmental Impact of LTTD
The results of the life-cycle environmental impact and step-by-step filtration analysis of the LTTD treatment by impact category are presented in
Table 5 and
Figure 6. The total life-cycle ADP environmental impact of the LTTD treatment was 1.29E-04 MJ/f. u. The transportation stage was the stage with the greatest environmental impact, contributing 5.50E-05 MJ/f.u. and accounting for 42.6% of the total environmental impact. The impact of diesel use in the oxidation chamber was 4.25E-05 MJ/f.u., accounting for 32.9%, and is thus the second-largest contributor after transportation. In addition to the aforementioned contributions, environmental impacts were influenced by electricity use (12.0%), rotary kiln diesel use (10.0%), and water use (2.0%).
The life-cycle environmental impact of GWP was 2.78.E+02 kg CO2-eq, with the largest contribution (49.1%) from diesel use in the oxidation chamber at 1.36.E+02 kg CO2-eq. The impact of the CO2 emission from the treatment stage was 5.03.E+01 kg CO2-eq, with a contribution of 18.1%, which was the second-largest share of the total GWP environmental impact. The environmental impacts of the remaining stages were dominated by rotary kiln diesel use (15.8%), electricity use (10.5%), and transportation (5.7%).
3.3. Life Environmental Impact Reduction Analysis
The results of the environmental impact reduction analysis according to purification temperature are presented in
Table 6 and
Table 7 and
Figure 7. The LTTD treatment reduced the total environmental impact by 3.40.E-05 MJ/f.u. for ADP compared with the HTTD treatment, whereas the GWP exhibited a total environmental impact reduction of 1.36.E+02 kg CO
2-eq/f.u.
The most significant reduction in the ADP impact category was observed in the treatment stage, where electricity use was reduced by 42.0% from 2.68.E-05 MJ/f.u. for HTTD treatment to 1.55.E-05 MJ/f.u. for the LTTD treatment, contributing to 33.2% of the total reduction. In the stages other than electricity use, the largest reductions were observed in the oxidation chamber (1.02.E-05 MJ/f.u.), kiln (7.46.E-06 MJ/f.u.), and transportation (1.90.E-06 MJ/f.u.), with contributions of 30.0%, 22.0%, and 7.4%, respectively. The remaining stages were analyzed to have a total reduction of 2.56 E-06 MJ/f.u., accounting for 7.5% of the total ADP reduction.
The most notable reduction in the GWP impact category was observed in the CO2 emission with the HTTD treatment amounting to 1.10E+02 kg CO2-eq/f.u. and the LTTD treatment decreasing to 5.03E+01 kg CO2-eq/f.u. This represented a reduction of 5.96E+01 kg CO2-eq/f.u. for the treatment stage, contributing to 43.7% of the total GHG emission reduction.
In steps other than the CO2 emission, the most significant emission reduction was observed in the oxidation chamber (3.26E+01 kg CO2-eq/f.u.) and kilns (2.39E+01 kg CO2-eq/f.u.). The most significant contributor to the CO2 emission was the oxidation chamber (3.26E+01 kg CO2-eq/f.u.), kiln (2.39E+01 kg CO2-eq/f.u.), and electricity (1.83E+01 kg CO2-eq/f.u.), with contributions of 24.0%, 17.6%, and 13.5%, respectively. The remaining stages were analyzed with a total reduction of 1.79E-06 kg CO2-eq/f.u., accounting for 1.3% of the total GWP reduction.
3.4. Characterization of LTTD-Treated Soil
In addition to comparing the environmental impact of the thermal desorption process according to the processing temperature, the characteristics of the treated soil obtained through the LTTD process were analyzed to study its applicability as a soil amendment. The characteristics of the LTTD-treated soil were analyzed, including the TPH level, toxicity evaluation, carbide yield, WHC, pH, and CEC. Based on the analysis results, we determined whether the LTTD-treated soil met the criteria for soil amendment [
21].
The char quality was analyzed for heavy metals and TPH, and it was confirmed that the heavy metals and TPH were within the remediation criteria of that country. However, because the types of heavy metals and organic compounds contained in oil-contaminated soil vary depending on the type of oil and regional characteristics, the results are limited to oilfield sites in Country A, which is the geographical scope of this study.
The WHC of the contaminated soil was 5–9%, and that of the LTTD-treated soil was determined to be 28.8% using gravimetric methods. This method involves weighing a moist sample, oven drying it at 105 °C for 24 h, reweighing, and calculating the mass of water lost as a percentage of the mass of the dried soil. Various studies have reported that biochar can increase agricultural soil water retention capacity [
22], indicating that LTTD-treated soil can fully utilize the water present, providing effective moisture for plant growth.
The CEC of the treated soil of LTTD was 97.2 cmol/kg, which was significantly higher than the average CEC of domestic soil (10 cmol/kg). This result indicates that the purified soil has the characteristics of a soil amendment agent because it enhances the fertility, adsorption capacity of nutrients, and the ability to inhibit the elution of nutrients, such as fertilizers. The CEC of biochar ranges from 50 to 204 cmol/kg [
23].
An ecotoxicity test was conducted using hydrocarbon-degrading microorganisms in the LTTD-treated soil. As shown in
Figure 8, microbial growth shows no issues because the colony-forming unit value increased from 5.0x105 to 2.0x108 after 5 days.
Finally, a seed germination experiment was conducted using the LTTD-treated soil. Twenty grams of the sample was added to the plate and ten radish seeds were sown. The seed germination experiment was conducted for 6 days at 25℃.
The results demonstrated that radish seed germination occurred in the LTTD-treated soil on day 3, with continued progression on day 6 in
Figure 9. In contrast, crude oil-contaminated soil did not germinate. This result demonstrated that the LTTD-treated soil did not exert a toxic effect on plants and that the germination rate was higher than that observed in the control soil.
The characteristics of the LTTD-treated soil and the performance criteria of the soil amendments identified in this study are presented in
Table 8 [
21,
24,
25].
4. Conclusion
In this study, a comparative environmental impact analysis of the entire thermal desorption process of high-concentration crude oil-contaminated soil according to processing temperature was conducted. The functional unit was set as the production of 1 ton of treated soil through HTTD and LTTD treatments. The system boundary was set from Cradle to Grave, from the excavation of high-concentration oil-contaminated soil to the waste landfill.
The analysis results showed that the total ADP environmental impact of HTTD treatment was 1.63.E-04 MJ/f.u., with the transportation phase contributing the most, at 34.9%. The transportation step was followed by the use of oxidation chamber diesel, electricity, and rotary kiln diesel, with contributions of 32.3%, 16.4%, and 12.5%, respectively. The environmental impact of the total GWP was 4.14.E+02 kg CO2-eq/f.u., with the most significant environmental impacts being the oxidation chamber diesel use (40.8%), CO2 emissions (26.5%), rotary kiln diesel use (15.8%), and electricity use (10.5%).
The total ADP environmental impact of the LTTD treatment was 1.29.E-04 MJ/f.u., with the transportation phase contributing the most, at 42.6%. The transportation stage was followed by the use of oxidation chamber diesel, electricity, and rotary kiln diesel, with contributions of 32.9%, 12.0%, and 10.0%, respectively. The environmental impact of the total GWP was 2.78.E+02 kg CO2-eq/f.u. The environmental impacts of oxidation chamber diesel (49.1%), CO2 emissions (18.1%), rotary kiln diesel (15.0%), and electricity use (9.1%) were found to be the most significant.
The results of the entire process environmental impact reduction analysis showed that replacing the HTTD process with the LTTD process reduced ADP by 3.40.E-05 MJ/f.u. (20.9%), and GWP by 1.36E+02 kg CO2-eq/f.u. (32.9%). The contributions to ADP reduction were electricity use, oxidation chamber diesel use, rotary kiln diesel use, and Water. The contributions to GWP reduction were CO2 emissions, PCC diesel use, rotary kiln diesel use, and electricity use.
LTTD treatment of contaminated soil is expected to significantly reduce the environmental impact of incineration and HTTD treatment. In addition, the CAPEX and OPEX of LTTD were lower than those of HTTD. Furthermore, analysis of the applicability of the LTTD-treated soil as a soil amendment showed that the LTTD-treated soil fully met the quality standards of soil amendment. It is expected that the utilization potential of LTTD-treated soil will be further maximized if further analysis of various oil-contaminated treated soils is conducted.
As a potential soil amendment, LTTD-treated soil is highly recommended to evaluate the real crop vegetation effect on water retention, nutrient retention, and higher yield, with long-term monitoring of the sustainability of the char structure on the soil surface.
Given the similarities between LTTD-treated soil and biochar, further investigation of the adsorption ability of the former for petroleum hydrocarbons and heavy metal compounds in water and soil is required [
26,
27].
Author Contributions
Conceptualization, Y.S. and G.K.; methodology, Y.S. software, G.K.; validation, D.K. and Y.H.; formal analysis, Y.S. and G.K.; investigation, Y.S.; data curation, Y.S. and G.K.; writing—original draft preparation, Y.S.; writing—review and editing, G.K. and D.K.; visualization, D.K.; supervision, Y.H. All authors have read and agreed to the published version of the manuscript.
Funding
This work was supported by Korea Environmental Industry & Technology Institute(KEITI) grant funded by the Korea Government (Ministry of Environment)(The Knowledge-based Environmental Service Specialized Graduate School Program).
Institutional Review Board Statement
Not applicable.
Informed Consent Statement
Not applicable.
Data Availability Statement
The data presented in this study are available on request from the corresponding author. The data are not publicly available due to business information.
Conflicts of Interest
The authors declare no conflict of interest.
References
- Ali N, Dashti N, Khanafer M, et al, Bioremediation of soils saturated with spilled crude oil. Sci. Rep., 2020, 10, 1-9.
- Saeed T, Al-Hashash H, Al-Matrouk K, et al, Assessment of changes in the chemical composition of crude oil spilled in the Kuwait Desert after weathering for five years. Environ. Int., 1998, 24, 141-152.
- Hongtao C, Xiaoyu W, Hongbao L, et al, Characterization and treatment of oily sludge: A systematic review, Environmental Pollution., 2023, 344, 123245.
- Nie F, Li Y, Tong K, et al, Volatile evolution during thermal treatment of oily sludge from a petroleum refinery wastewater treatment Plant: TGA-MS, Py-GC (EGA)/MS and kinetics study, Fuel, 2020, 278, 118332.
- Zhu N, Wang J, Wang Y, et al, Differences in geological conditions have reshaped the structure and diversity of microbial communities in oily soils, Environmental Pollution, 2022, 306, 119404.
- Li Y, Zhang Q, Guo D, et al, Characteristics and Risk Assessment of PAH Pollution in Soil of a Retired Coking Wastewater Treatment Plant in Taiyuan, Northern China. Toxics, 2023, 11(5), 415.
- Książek-Trela P, Figura D, Węzka D, et al, Degradation of a mixture of 13 polycyclic aromatic hydrocarbons by commercial effective microorganisms. Open Life Sciences, 2024, 19(1), 20220831.
- L. Faboya O, Samuel O. S, Joseph O. O, et al, Preliminary investigation of polycyclic aromatic hydrocarbons (PAHs) concentration, compositional pattern, and ecological risk in crude oil-impacted soil from Niger delta, Nigeria, J. Heliyon., 2023, 9, e15508.
- Ali N, Dashti N, Khanafer M, et al, Bioremediation of soils saturated with spilled crude oil, Sci. Rep., 2020, 10, 1116.
- Li F, Zhang Y, Wang S, et al, Insight into ex-situ thermal desorption of soils contaminated with petroleum via carbon number-based fraction approach, Chemical Engineering Journal, 2020, 385, 123946.
- Ding D, Song X, Wei C, et al, A review on the sustainability of thermal treatment for contaminated soils, Environ. Pollut., 2019, 253, 449-463.
- Kang CU, Kim DH, Khan MA, et al, Pyrolytic remediation of crude oil-contaminated soil, Sci Total Environ., 2020, 173, 136498.
- Kurniasih A, Nugroho SH, Setyawan R, Marine ecology conditions at Weda Bay, North Maluku based on statistical analysis on distribution of recent foraminifera, MATEC Web of Conferences, 2017, 101, 04014.
- Huang S, Zhang Y, Sheng JJ, Experimental Investigation of Enhanced Oil Recovery Mechanisms of Air Injection under a Low-Temperature Oxidation Process: Thermal Effect and Residual Oil Recovery Efficiency, Energy Fuels, 2018, 32, 6774-6781.
- Wang S, Cheng F, Shao Z, et al, Effects of thermal desorption on ecotoxicological characteristics of heavy petroleum-contaminated soil, Sci Total Environ., 2023, 857, 159405.
- International Organization for Standardization (ISO). ISO14040:2006 Environmental Management—Life Cycle Assessment—Principles and Framework, 2nd ed.; ISO: Geneva, Switzerland, 200.
- Tian L, Huo M, Lu Y, et al, Life cycle assessment-based decision-making for thermal remediation of contaminated soil in a regional perspective, J. Clean. Prod., 2023, 392, 136260.
- Adeniran JA, Mustapha SI, Yusuf RO, et al, Life Cycle Assessment of a Petroleum-Contaminated Soils Thermal Desorption Unit, J. Exp. Res., 2020, 18.
- Amponsah NY, Wang J, Zhao L, A review of life cycle greenhouse gas (GHG) emissions of commonly used ex-situ soil treatment technologies. J. Clean. Prod., 2018, 186, 514–525.
- Hu G, Liu H, Rana A, et al, Life cycle assessment of low-temperature thermal desorption-based technologies for drill cuttings treatment, J Hazard Mater., 2021, 401, 123865.
- Bertola M, Ferrarini A, Visioli G, Improvement of soil microbial diversity through sustainable agricultural practices and its evaluation by -omics approaches: a perspective for the environment, food quality and human safety, 2021, 9, 1400.
- Ndede EO, Tokunari T, Kurebito S, et al, The Potential of Biochar to Enhance the Water Retention Properties of Sandy Agricultural Soils, J. Agron ., 2022, 12, 31.
- Munera-Echeverri JL, Martinsen V, Strand LT, et al, 2018 Nov 15:642:190-197, Cation exchange capacity of biochar: An urgent method modification, Sci Total Environ., 2018, 642, 190-197.
- Carril P, Ghorbani M, Loppi S, et al, Effect of Biochar Type, Concentration and Washing Conditions on the Germination Parameters of Three Model Crops, Plant J., 2023, 12, 2235.
- Yadav SPS, Bhandari S, Bhatta D, et al, Biochar application: A sustainable approach to improve soil health, J. Agric. Res., 2023, 11, 100498.
- Vadakkan K, Sathishkumar K, Raphael R, et al, Review on biochar as a sustainable green resource for the rehabilitation of petroleum hydrocarbon-contaminated soil, , Sci Total Environ., 2024, 941, 173679.
- Wei Z, Yi W, Yang L, et al, Biochar-based materials as remediation strategy in petroleum hydrocarbon-contaminated soil and water: Performances, mechanisms, and environmental impact, J. Environ. Sci., 2024, 138, 350-372.
|
Disclaimer/Publisher’s Note: The statements, opinions and data contained in all publications are solely those of the individual author(s) and contributor(s) and not of MDPI and/or the editor(s). MDPI and/or the editor(s) disclaim responsibility for any injury to people or property resulting from any ideas, methods, instructions or products referred to in the content. |
© 2024 by the authors. Licensee MDPI, Basel, Switzerland. This article is an open access article distributed under the terms and conditions of the Creative Commons Attribution (CC BY) license (http://creativecommons.org/licenses/by/4.0/).